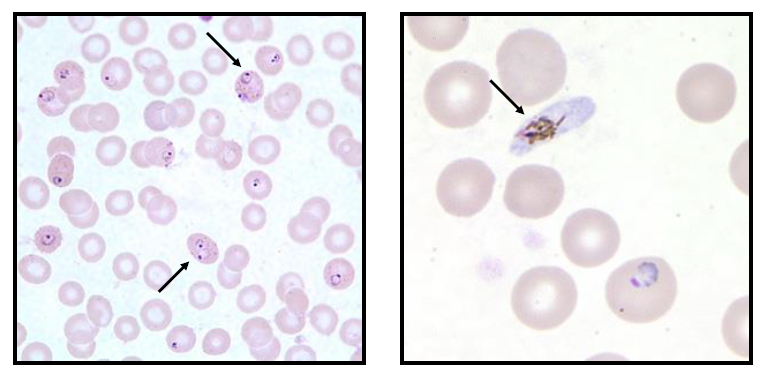

As imagens abaixo representam dois campos observados pelo analista clínico durante seu dia a dia, na bancada de hematologia.
Figura 1 e 2. Fonte: https:// www.cdc.gov/dpdx/malaria/index.html
As setas apontam para estruturas morfológicas características (trofozoítos em forma de anel e gametócito) do parasita
A
Leishmania infantum, agente etiológico da leishmaniose visceral.
B
Plasmodium facilparum, agente etiológico da malária.
C
Plasmodium vivax, agente etiológico da filariose.
D
Toxoplasma gondii, agente etiológico da toxoplasmose.